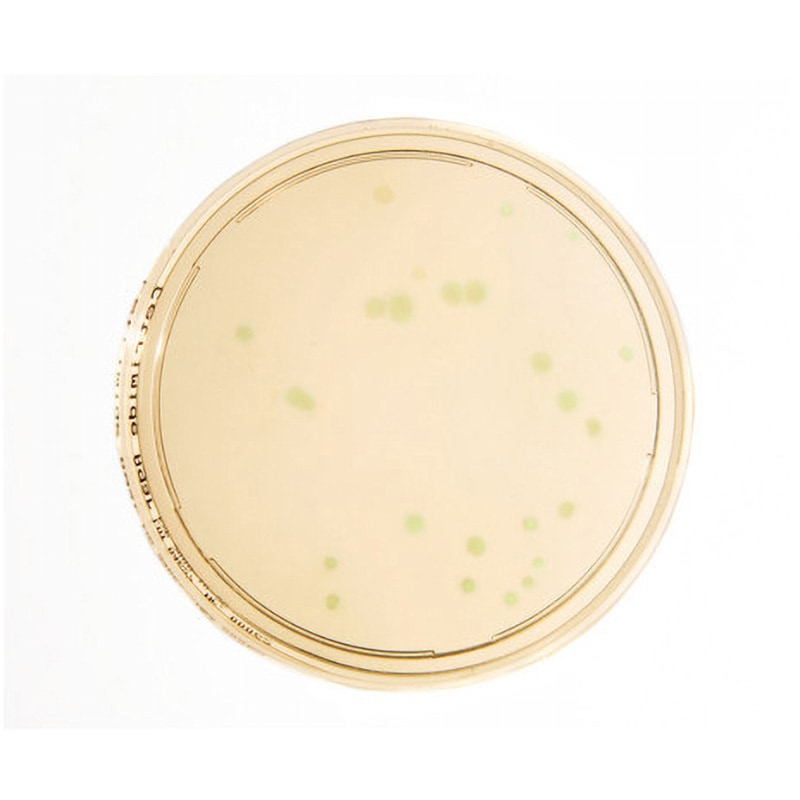
【for清田様】オーダー品 Amazon.com: NICHE 434cc Big Bore Cylinder Piston Kit for Arctic

マイストア
変更
お店で受け取る
(送料無料)
配送する
納期目安:
2025.12.12 18:18頃のお届け予定です。
決済方法が、クレジット、代金引換の場合に限ります。その他の決済方法の場合はこちらをご確認ください。
※土・日・祝日の注文の場合や在庫状況によって、商品のお届けにお時間をいただく場合がございます。
【for清田様】オーダー品 Amazon.com: NICHE 434cc Big Bore Cylinder Piston Kit for Arcticの詳細情報
Amazon.com: NICHE 434cc Big Bore Cylinder Piston Kit for Arctic。Amazon.com: Niche Big Bore Top End Gasket Kit for Arctic Cat 400。LTZ DRZ KFX 400 LTZ400 Big Bore 94mm Cylinder Complete Top End。ありがとうございますm(__)mこちらは 清田のお品物です。s-l1200.jpg。どうぞ宜しくお願い致します(^^)◆14kgfリング 5号ルベライト0.42ct(6.1×4.1×2.8㎜) +3000円ツァボライト0.28ct(4.0×2.2㎜) +3000円特別加工(アーム太め)+1000円添石はトルマリン×2(+100円)→9,900円→リピーター様お値引き後9,800円#花雪ラッピング#花雪リング
ベストセラーランキングです
近くの売り場の商品
カスタマーレビュー
オススメ度 4.7点
現在、2687件のレビューが投稿されています。